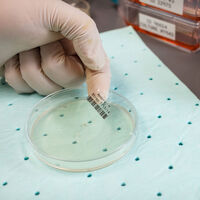

M6-17-430 | |
|---|---|
DigiKey Part Number | 2267-M6-17-430-ND |
Manufacturer | |
Manufacturer Product Number | M6-17-430 |
Description | LABEL 0.5X1 POLYESTER RL/500 |
Manufacturer Standard Lead Time | 3 Weeks |
Customer Reference | |
Datasheet | Datasheet |
Type | Description | Select All |
|---|---|---|
Category | ||
Manufacturer | Brady Corporation | |
Series | - | |
Packaging | Box | |
Part Status | Active |
| Quantity | Unit Price | Ext Price |
|---|---|---|
| 1 | 52,00000 € | 52,00 € |
| Unit Price without VAT: | 52,00000 € |
|---|---|
| Unit Price with VAT: | 62,40000 € |

